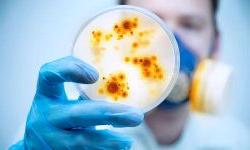
Врач-инфекционист

Непростая работа врача-инфекциониста
Врач-инфекционист занимается диагностикой, лечением и профилактикой инфекционных заболеваний. Инфекционные заболевания вызывают различные болезнетворные микроорганизмы, передающиеся от зараженного организма к здоровому. Каждое заболевание вызывается своим возбудителем и имеет характерные пути передачи.
Врач-инфекционист занимается диагностикой, лечением и профилактикой инфекционных заболеваний. Инфекционные заболевания вызывают различные болезнетворные микроорганизмы, передающиеся от зараженного организма к здоровому. Каждое заболевание вызывается своим возбудителем и имеет характерные пути передачи.
С какими симптомами обращаются к врачу-инфекционисту? Букет жалоб, с которыми обращаются к этому специалисту, очень разнообразен. Все их можно объединить в следующие группы:
- Синдром общей интоксикации, включающий в себя головную боль, болезненность в мышцах, суставах.
- Сыпь. Для различных заболеваний характерны различные проявления и локализация кожных проявлений.
- Местная реакция организма на проникновение инфекции.
- Реакция различных систем организма на инфекцию (симптомы поражения головного мозга, поражение желудочно-кишечного тракта, поражение сердечно-сосудистой, лимфатической, дыхательной систем, опорно-двигательного аппарата).
Для установления точного диагноза врач-инфекционист проводит ряд лабораторных и инструментальных методов обследования.
Лечение ведется сразу по нескольким направлениям. Обязательно назначается медикаментозная терапия. Если больной может служить источником распространения инфекции, его обязательно изолируют. Такие больные требуют особых условий лечения: строгий режим, соблюдение правил санитарной обработки.
При возникновении различных эпидемий, врач данной специализации занимается профилактикой и лечением больных в очаге возникновения инфекции.
Для специалистов данного профиля в нашем учебном центре проходит курс повышения квалификации по инфекционным болезням. Программа обучения строится с применением дистанционных образовательных технологий, а начать изучение материала можно в любой день.